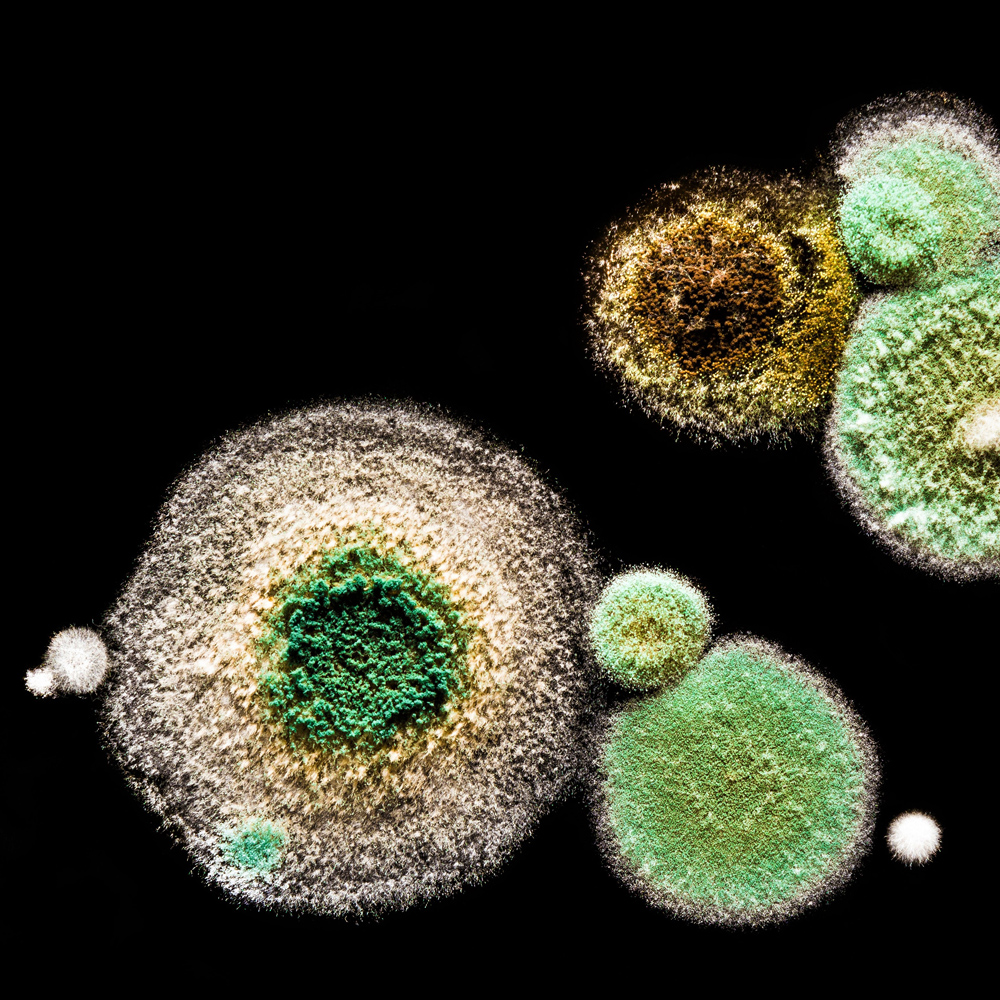

24/7 Emergency Response

Mold Remediation
Licensed & Certified Mold Remediation
Any excess moisture, from flooding or just a humid bathroom, is all mold needs to get going and creating major problems. It can even be growing under flooring and within walls completely out of sight. But make no mistake. Neglect can lead to building damage and potentially very serious health issues. If you have any suspicions at all, you need a highly trained mold remediation expert to check out your home or place of business. And if you’ve had any water damage related problem you have just 24-48 hours to head off problems. Any mold-related work should only be done by an insured, and licensed restoration company with an established reputation. They should have a contractors license and be approved specifically in mold remediation.
Regal Emergency Services provides the expert 24/7 fast response services by certified technicians that you need.
We’re an independently owned and operated local company. Our well-trained and experienced technicians are true specialists, as necessary for the exacting requirements and technical difficulties of mold removal. We back up their professional pride with ongoing education and the latest equipment. Regal Emergency Services is fully licensed, insured, and bonded. We’re a licensed contractor and State of California approved for mold remediation with certified specialists in a variety of areas. Correcting mold damage often involves also removing building materials. As a general contractor we’re also well qualified for all follow-up repairs and reconstruction, so there’s no need for you to coordinate additional companies.
Mold Remediation Costs and Insurance
The hazards of mold removal aren’t obvious to the eye. Due the ease with which it spreads, especially when disturbed, and the serious health risks of exposure remediation is highly regulated. Extensive technical knowledge is required, and specified procedures (including worker protection) must be followed to the letter. Set-up tasks don’t vary all that much with the size of the affected area, and that’s why service for even small areas typically starts at around a thousand dollars. And as we’ll see the bulk of an infestation may be completely hidden.
Professional services are well worth the cost to protect the health of you and your family or employees, and to assure that the job is done absolutely thoroughly to prevent recurrence and spread. The EPA recommends that do-it-yourself approaches be limited to growth covering less than 10 square feet (around 3 1/2 feet in diameter), and only with fully understanding all the steps and sticking to them.
Insurance coverage for mold services varies widely and usually includes specific treatment requirements, making these claims especially complex. Having years of experience with local adjusters and pretty much every major insurance company, Regal Emergency Services is ready to help you with the paper work and navigating through any difficulties. We provide all the necessary documentation, and will bill your insurance directly.
Symptoms and Hazards
Mold has become an important issue in recent years, partly as a result of increased understanding of its dangers. But additionally, with today’s more air-tight energy-conserving buildings any design or construction flaws (or a failed ventilation system) quickly leads to excess humidity and moisture making mold problems occur much more often. Cleaning anything other than small patches on bath or kitchen hard surfaces yourself leaves you with significant health risks and open to building damage.
Fuzzy areas of various colors are easy to spot, but it’s important to remember that problems can be hidden under carpet or other flooring, inside walls, above the ceiling, in crawl spaces, and so on. If you notice a musty odor, you quite likely have a mold problem. Or you may only notice health issues such as allergies, ongoing cold or flu-like symptoms, or eye, nose, or throat irritations. Respiratory and immune system problems can also result. More insidious, mycotoxins can lead to slow but permanent organ damage.
Black mold has a justifiably notorious reputation for being exceptionally toxic. If you see it, never touch it, and leave black mold removal to the experts. But many other species (and colors) are also very hazardous. And most release airborne spores (a common allergen) and their growth damages building materials and contents.

Causes
All species of mold (also called mildew) are a type of fungus, and as such don’t need light to grow. They actually prefer dark spaces. All they need is some food to eat (typically cellulose as found in wood, paper, cloth, and so on) and moisture. Their “seeds” are spores too small to see, that readily float on the slightest air currents. Those spores are just about everywhere outdoors, and readily find their way indoors. That’s why outbreaks are caused by any excess moisture such as from high humidity, a leaky roof or window, major or even minor plumbing leaks, or flooding. And also why a major mold-creating water damage problem can be completely hidden from view. Given the right temperature molds can suddenly grow amazingly fast.
The Mold Remediation Process
Cleaning with bleach can indeed kill mold, but you’re still left with allergens and most likely hidden or returning growth. Similarly, “killer” paints block the discoloration and surface moisture, but dampness from elsewhere can still leave you with major headaches.
With the many species of mold and differences in design, construction, and materials no two homes or business locations are exactly the same. That’s why our extensive training and experience are so important in determining the best mold remediation process.
Testing and Planning
There’s actually no need for the expense of countless samples, but we do begin with inspection and several mold tests to properly identify the species as well as the extent and location of its growth. That means visual inspections and thermal imaging (that detects hidden moisture) as well as testing air, dust, swab, tape, and bulk samples. From there our experts determine the best protocols and procedures, following regulations and best practices in detail, with step by step checklists.
Isolation and Protection
Whenever disturbed, mold releases a burst of spores, allergens, and often toxins. These can easily spread throughout the building, making isolation critical in avoiding future problems. Protecting occupants and the remainder of the building involves putting up plastic sheets around the work area and pulling air to the outside with negative-pressure exhaust fans as well as continuously running HEPA air filters. Workers within the area require protective clothing, gloves, and special face masks with filters. The work area requires constant cleanup and care.
Mold Removal and Disposal
We remove mold using professional methods, treat all affected areas (including ducts), safely dispose of waste, and use HEPA filtration to eliminate remaining spores and prevent future growth.
Decontamination and Odor Control
We typically follow up with cleaning and treatment for carpets and rugs, inside cabinets, and other areas mold spores like to settle down and hide. We also apply non-toxic environmental anti-microbials in and around the affected areas as an added safeguard. We may also use ozone or hydroxyl generators to fully neutralize odors in every nook and cranny.
Verification
Additional testing is performed afterward to assure that the job was thorough and complete.
Request Service Today
(800)707-3425

